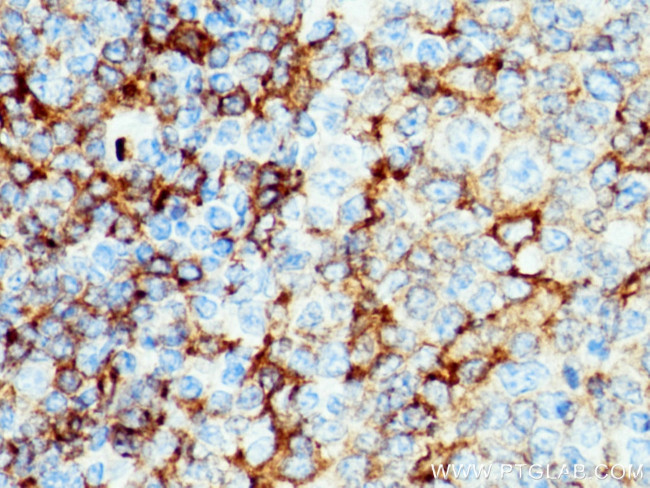
NOX2 Antibody in Immunohistochemistry (Paraffin) (IHC (P))

Search
Proteintech
NOX2 Polyclonal Antibody
{{$productOrderCtrl.translations['antibody.pdp.commerceCard.promotion.promotions']}}
{{$productOrderCtrl.translations['antibody.pdp.commerceCard.promotion.viewpromo']}}
{{$productOrderCtrl.translations['antibody.pdp.commerceCard.promotion.promocode']}}: {{promo.promoCode}} {{promo.promoTitle}} {{promo.promoDescription}}. {{$productOrderCtrl.translations['antibody.pdp.commerceCard.promotion.learnmore']}}
产品信息
19013-1-AP
种属反应
已发表种属
宿主/亚型
分类
类型
抗原
偶联物
形式
浓度
规格
纯化类型
保存液
内含物
保存条件
运输条件
产品详细信息
Immunogen sequence: SILKSVWYK YCNNATNLKL KKIYFYWLCR DTHAFEWFAD LLQLLESQMQ ERNNAGFLSY NIYLTGWDES QANHFAVHHD EEKDVITGLK QKTLYGRPNW DNEFKTIASQ HPNTRIGVFL CGPEALAETL SKQSISNSES GPRGVHFIFN KENF (422-577 aa encoded by B C032720)
靶标信息
Mox1 and the glycoprotein gp91-phox are largely related proteins that are essential components of the NADPH oxidase. The superoxide-generating NADPH oxidase complex expresses in phagocytes, neuroepithelial bodies, vascular smooth muscle cells, and endothelial cells. It includes a membrane bound flavocytochrome containing two subunits, gp91-phox and p22-phox, and the cytosolic proteins p47-phox and p67-phox. The p22- and gp91-phox subunits also function as surface O2 sensors that initiate cellular signaling in response to hypoxic conditions. Mox1 and gp91 contain identical C-terminal sequence identity, yet possess distinct expression patterns. gp91-phox expresses in eosinophils, neutrophils, monocytes, and B-lymphocytes, whereas Mox1 is predominantly detected in the colon, with low expression in the uterus and prostate.
仅用于科研。不用于诊断过程。未经明确授权不得转售。
生物信息学
蛋白别名: CGD91-phox; Cytochrome b(558) subunit beta; cytochrome b-245 beta polypeptide; Cytochrome b-245 heavy chain; cytochrome b-245, beta polypeptide; Cytochrome b558 subunit beta; endothelial type gp91-phox; GP91 PHOX; gp91-1; gp91-phox; GP911; Heme-binding membrane glycoprotein gp91phox; NADPH oxidase 2; Neutrophil cytochrome b 91 kDa polypeptide; p22 phagocyte B-cytochrome; p91PHOX; Superoxide-generating NADPH oxidase heavy chain subunit; unnamed protein product
基因别名: AMCBX2; C88302; CGD; CGD91-phox; CGDX; CYBB; Cyd; GP91-1; GP91-PHOX; GP91PHOX; IMD34; NOX2; p91-PHOX
UniProt ID: (Human) P04839, (Mouse) Q61093
Entrez Gene ID: (Human) 1536, (Rat) 66021, (Mouse) 13058